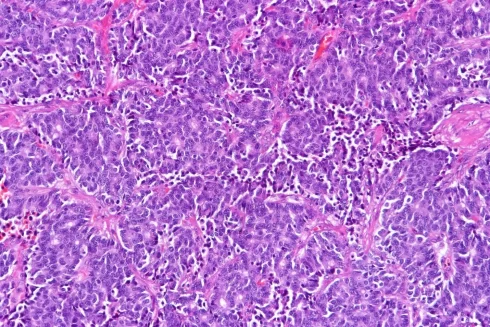
تومورهای کارسینوئید ریه چیست؟ انواع، علائم و درمان

آرشیو دسته بندی: بیماری ها
باسیلوس سوبتیلیس (Bacillus subtilis): یک مرور کلی و کاربردها
مقدمهای بر باسیلوس سوبتیلیس باسیلوس سوبتیلیس گونهای از جنس باسیلوس است که معمولاً در محیطهای[بیشتر بخوانید]
6 دیدگاه
ناهنجاری های کروموزومی ساختاری و انواع آن
مقدمهای بر ناهنجاری های کروموزومی ساختاری ناهنجاری های کروموزومی به طور کلی به دو دسته[بیشتر بخوانید]
ناهنجاری های کروموزومی عددی و انواع آن
مقدمهای بر ناهنجاری های کروموزومی عددی ناهنجاری های کروموزومی به طور کلی به دو دسته[بیشتر بخوانید]
14 دیدگاه
تومور کارسینوئید دستگاه گوارش چیست؟ علائم، پیشگیری و درمان
تومور کارسینوئید دستگاه گوارش تومور کارسینوئید دستگاه گوارش نوعی سرطان است که در پوشش داخلی[بیشتر بخوانید]
6 دیدگاه
روتاویروس چیست؟ ساختار، ژنوم، اپیدمیولوژی و علائم
ساختار روتاویروس نام روتاویروس از کلمه لاتین rota به معنای “چرخ” گرفته شده است. این[بیشتر بخوانید]
بلاستومایسس درماتیتیدیس: زیستگاه، مورفولوژی و بیماریزایی
مقدمهای بر بلاستومایسس درماتیتیدیس بلاستومایسس درماتیتیدیس قارچی دیمورف است که باعث بلاستومایکوزیس، یک عفونت قارچی[بیشتر بخوانید]
2 دیدگاه
کریپتوکوکوس نئوفرمانس: زیستگاه، مورفولوژی، اپیدمیولوژی و درمان
زیستگاه کریپتوکوکوس نئوفرمانس کریپتوکوکوس نئوفرمانس یک قارچ کپسوله شده محیطی است که در همه جا[بیشتر بخوانید]
3 دیدگاه
باسیلوس سرئوس: زیستگاه، ساختار، درمان و پیشگیری
زیستگاه باسیلوس سرئوس باسیلوس سرئوس میتواند در خاک، سبزیجات، شیر، غلات، ادویهجات ترشیجات، برنج، مرغ[بیشتر بخوانید]
2 دیدگاه
برادی کاردی چیست؟ انواع، علائم، تشخیص و درمان
مقدمهای بر برادی کاردی برادی کاردی به ضربان قلب کندتر از حد طبیعی گفته میشود.[بیشتر بخوانید]
8 دیدگاه
مزوتلیومای بدخیم چیست؟ تعریف، علائم، پیشگیری و درمان
مقدمهای بر مزوتلیومای بدخیم مزوتلیومای بدخیم سرطانی است که در سلولهای پوششی بخشهای خاصی از[بیشتر بخوانید]
4 دیدگاه
لیکن پلان چیست؟ انواع، علائم تشخیص و درمان
خلاصه مطالب لیکن پلان می تواند ناراحت کننده باشد، اما اغلب خطرناک نیست. با گذشت[بیشتر بخوانید]
3 دیدگاه
تومورهای کارسینوئید ریه چیست؟ انواع، علائم و درمان
مقدمهای بر تومورهای کارسینوئید ریه تومورهای کارسینوئید ریه (که همچنین به عنوان کارسینوئید ریه یا[بیشتر بخوانید]
20 دیدگاه
تومور ویلمز چیست؟ انواع، علائم، درمان
مقدمهای بر تومور ویلمز (Wilms Tumors) تومور ویلمز (که nephroblastoma یا نفروبلاستوما نیز نامیده میشود)[بیشتر بخوانید]
12 دیدگاه
تفاوت بیماری حاد و بیماری مزمن
مقدمهای بر تفاوت بیماری حاد و بیماری مزمن بیماری حاد چیست؟ بیماری حاد وضعیت یا[بیشتر بخوانید]
4 دیدگاه
هایپوترمی چیست؟ انواع، تشخیص، علائم و علل
هایپوترمی چیست؟ هایپوترمی (دمای پایین بدن) هم به یک وضعیت پزشکی و هم به یکی[بیشتر بخوانید]
مورفولوژی غیر طبیعی RBC
مقدمهای بر مورفولوژی غیر طبیعی RBC برای متخصصان هماتولوژی آزمایشگاهی، شمارش کامل خون (CBC) و[بیشتر بخوانید]
10 دیدگاه
سارکوم رحم (Uterine Sarcoma) چیست؟
مقدمهای بر سارکوم رحم سرطان زمانی شروع میشود که سلولهای بدن شروع به رشد خارج[بیشتر بخوانید]
23 دیدگاه
بیماری کیسه صفرا: علائم، تشخیص و درمان
بیماری کیسه صفرا به هر شرایط پزشکی اشاره دارد که میتواند کیسه صفرا را تحت[بیشتر بخوانید]
4 دیدگاه
سندروم مارفان: علائم، علل، تشخیص و درمان
سندروم مارفان، بافت همبند (بافتی که باعث انسجام و پشتیبانی از اندامهای داخلی میشوند) را[بیشتر بخوانید]
1 دیدگاه
سرطان آلت تناسلی (Penile Cancer) چیست؟
مقدمهای بر سرطان آلت تناسلی سرطان آلت تناسلی در داخل یا روی آلت تناسلی شروع[بیشتر بخوانید]
2 دیدگاه
سرطان بیضه (testicular cancer) چیست؟
مقدمهای بر سرطان بیضه سرطان زمانی شروع میشود که سلولها شروع به رشد خارج از[بیشتر بخوانید]
4 دیدگاه